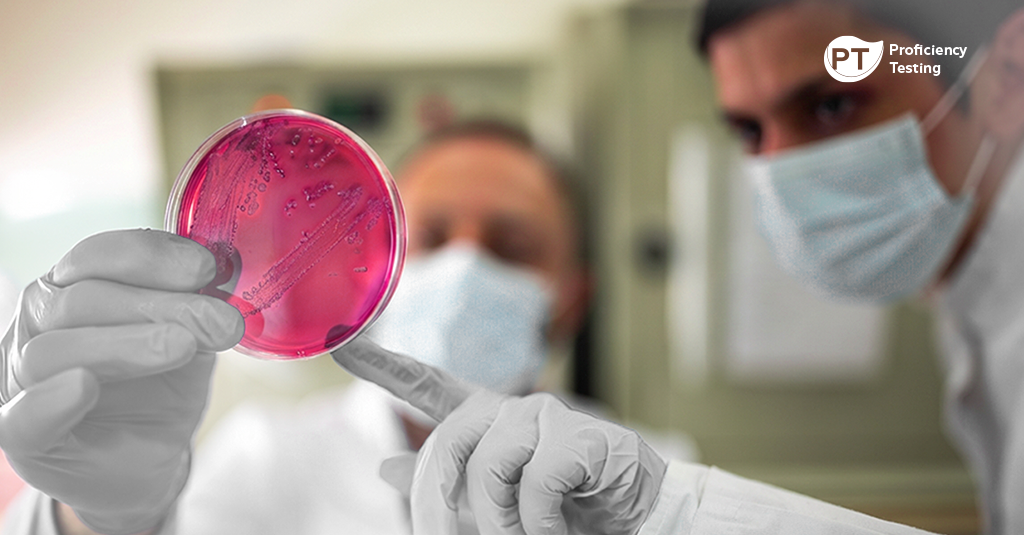

Since the beginning of the pandemic, organizations have been challenged in their routines. The laboratories, in the midst of these adjustments and adaptations of the teams, quickly introduced detection for SARS-CoV2 (COVID-19) in their analysis.
Given this scenario, 124 laboratories participated in the first Proficiency Test (EP) conducted in Brazil for SARS-CoV2, an initiative by Controllab in partnership with the Brazilian Society of Clinical Pathology/Laboratory Medicine. The participating laboratories contributed with fundamental information to demonstrate to the market the performance of the analytical systems used. Controllab congratulates these laboratories for their participation and for being committed to the credibility and quality of their reports, supporting the diagnosis for SARS-CoV2 with reliable information. Participants in the initiative are listed on the map below.
The behavior obtained in the interlaboratory comparison was analyzed by a group of specialists in the diagnostic sector and made available in a report. The content is enriched with information to assist manufacturers of diagnostic kits and, especially, laboratories, demonstrating the relevance of quality control in periods of uncertainty and complexity. Access the published document by clicking on the image of the report.

Access here
the report of the first pioneering proficiency test evaluation in all SARS-CoV2 detection methods
To serve the new participants, on June 15 the second round of external controls of COVID-19 will be sent. This is an opportunity for more laboratories to immediately strengthen their quality management systems. By signing up, you build, together with current participants, a broader picture of important data and information for the sector.
Participate, contribute and help the laboratory diagnostic market!
Interested laboratories can register directly on this page.